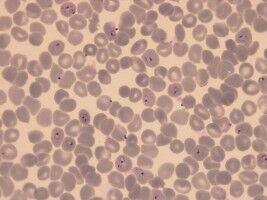
New Drug Candidate to Tackle Resistant Malaria Strains

news
Swiss TPH
Results 1 - 20 of 94.
Pharmacology - Health - 21.10.2025
Bacterial pathogens becoming resistant to antibiotics is well known. But resistance is also emerging among parasites - including those that cause malaria. As existing medicines lose effectiveness, researchers from Swiss TPH and the Helmholtz Institute for Pharmaceutical Research Saarland (HIPS) and partners have developed a new drug candidate that can kill malaria parasites even when standard treatments fail.
Health - 03.06.2025
Children’s Exposure to Pesticides in Vineyard and Orchard Regions
A study carried out by Swiss TPH on behalf of the Canton of Valais aimed at measuring pesticide exposure in children living near vineyards or orchards. Results show that all children in the study have been exposed to pesticides. However, no short-term association between pesticide exposure and respiratory symptoms such as coughing or breathing difficulties were found.
Agronomy & Food Science - Health - 04.04.2025

Swiss farmers report lower levels of wellbeing than their urban and rural counterparts in the general population, with psychosocial hazards such as stress and poor sleep identified as the strongest negative influences. These are the baseline findings of the FarmCoSwiss cohort study, published today in Swiss Medical Weekly by researchers at Swiss TPH.
Health - Pharmacology - 02.01.2025

Tuberculosis (TB) is the world's biggest infectious disease killer with multidrug-resistant TB (MDR-TB) posing a particular threat to global health. A study led by the Swiss Tropical and Public Health Institute (Swiss TPH) shows that resistance to the new MDR-TB treatment regimen recently recommended by the World Health Organization is already spreading between patients.
Health - 15.10.2024

Maintaining physical activity throughout life is crucial for health and well-being. However, the age-related decline in average physical activity is a challenge. In our study, we found that organised sports, supported by the Swiss Youth+Sports (Y+S) programme, plays an important role in counteracting this trend.
Health - Life Sciences - 02.10.2024

To estimate the efficacy of antimalarial drugs, distinguishing recurring from new infections is crucial. Researchers from Swiss TPH have now compared five genotyping methods to make this distinction and assessed their impact on drug efficacy. The results, published yesterday in the peer-reviewed journal The Lancet Microbe, could help confirm antimalarial resistance and inform WHO guidelines.
Health - Psychology - 12.09.2024
New Intervention Significantly Improved Mental Health Well-Being for Zambian Mothers
A study by Swiss TPH and partners has shown that a new, locally adapted mental health intervention for women with young children in Zambia led to a 50% reduction in mental health symptoms. The intervention also empowered the women, resulting in a positive impact on the relationship with their children and their economic situation.
Environment - 16.08.2024

More than half of the global population is estimated to lack safe drinking water services in a study published yesterday in the journal Science. The results are depicted in a map that researchers compiled using machine learning based on data from household surveys and data derived from earth observations.
Pharmacology - Health - 16.08.2024

Researchers at Swiss TPH have demonstrated that the novel drug candidate, emodepside, is highly effective in treating parasitic worm infections in humans, particularly hookworms. The results of a Phase 2b trial, published today in The Lancet, confirmed the drug's strong efficacy and safety profile, building on the promising outcomes of an earlier Phase 2a study.
Health - 06.06.2024

Chronic pain is a significant global health concern and access to pain control is a basic human right. While the burden of chronic pain is well described in high-income countries, there is limited data in lowand middle-income countries (LMICs), in particular in marginalized communities such as pastoralists.
Health - Environment - 31.05.2024

An estimated one-fifth of the world's population is affected by pollen allergies. Researchers at Swiss TPH have now discovered that high pollen concentrations can increase blood pressure in allergy sufferers. Pollen allergies are thus becoming a growing public health problem, especially as the pollen season is becoming longer and more intense due to climate change.
Pharmacology - Health - 03.04.2024

A recent breakthrough sheds light on how the malaria parasite, Plasmodium falciparum, invades human red blood cells. The study, led by the Swiss Tropical and Public Health Institute (Swiss TPH) and Griffith University's Institute for Glycomics, reveals the role of a sugar called sialic acid in this invasion process.
Health - Research Management - 20.03.2024

A study published yesterday by Swiss TPH and partners in Lao PDR has revealed high rates of Steatotic Liver Disease in a rural region where liver fluke infections and diabetes are prevalent. Surprisingly, an infection with parasitic worms was inversely associated with the prevalence of Steatotic Liver Disease.
Health - 29.01.2024

Cervical cancer is the leading cause of cancer related deaths among women in sub-Saharan Africa. Women living with the human immunodeficiency virus (HIV) are six times more likely to develop cervical cancer than those who are HIV negative. To tackle this issue, Swiss TPH together with partners developed the Cervical Cancer Prevention and Care Cascade - a framework to enhance cervical cancer screening programmes for women living with HIV in sub-Saharan Africa.
Health - Pharmacology - 18.12.2023

A large-scale study by the DYNAMIC project has produced promising results: the use of a new digital clinical decision-making tool has led to a twoto three-fold reduction in the prescription of antibiotics. These results, just published in the peer-reviewed journal Nature Medicine, marks an important step towards curbing bacterial antimicrobial resistance.
Health - 12.12.2023

Studies published in the Lancet Global Health finds that only one-quarter of people thinks their health system works well. The People's Voice Survey analysed people's views and trust in the system in 15 countries, adding a missing component to how one evaluates health system performance. Swiss TPH contributed to these studies.
Health - 12.12.2023

A series of papers in the Lancet Global Health published yesterday finds that only one-quarter of people thinks their health system works well. The People's Voice Survey analysed people's views and trust in the system in 15 countries, adding a missing component to how one evaluates health system performance.
Health - Veterinary - 30.08.2023

Elimination of rabies in Africa could be within reach through a more coordinated One Health approach. An innovative study by Swiss TPH and partners applied game theory to tackle rabies challenges and identified effective strategies for affected countries. The paper, published in Nature Communications, demonstrates that a more coordinated approach could end this fatal disease and result in major health, economic and social gains.
Health - Pharmacology - 30.06.2023

Scientists have identified a new class of compounds called cyanotriazoles that have the potential to effectively inhibit the growth of trypanosomes, the parasites responsible for Chagas disease and African sleeping sickness. The results, published yesterday in the journal Science, demonstrate that the compounds show no toxicity to human cells, raising hopes for the development of new and improved treatments for neglected tropical diseases.
Pharmacology - Health - 17.05.2023

A new drug candidate shows promising results in treating parasitic worm infections. Re-searchers at Swiss TPH tested efficacy and safety of emodepside against the three most important soil-transmitted helminths on Pemba Island in Tanzania. Emodepside is the first new promising drug against parasitic worm infections since several decades.
Health - Today
AI was supposed to ease doctors' workload - instead they spend hours correcting errors
AI was supposed to ease doctors' workload - instead they spend hours correcting errors
Pharmacology - Today
International trial finds rapid diagnostic testing alone does not reduce antibiotic prescribing for respiratory infections
International trial finds rapid diagnostic testing alone does not reduce antibiotic prescribing for respiratory infections
Social Sciences - Today
Social background shapes how hard children work, according to a study by UC3M
Social background shapes how hard children work, according to a study by UC3M

Innovation - Today
With Robotics Innovation Center, CMU and Hazelwood Partners Sustain Community Collaborations
With Robotics Innovation Center, CMU and Hazelwood Partners Sustain Community Collaborations















